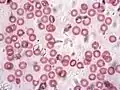
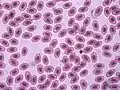

دم
الدم هو سائل في الجسم الإنسان والحيوانات ينقل المواد الضرورية مثل المغذيات والأكسجين إلى الخلايا وينقل الفضلات الأيضية مثل ثاني أكسيد الكربون
| دم | |
|---|---|
| الاسم اللاتيني haema | |
 قطرتان من الدم، اليسرى ذات لون أحمر قاني "دم مؤكسج"(شرياني) أما اليمنى ذات لون أحمر قاتم "دم غير مؤكسج"(وريدي). | |
| تفاصيل | |
| يتكون من | بلازما الدم ، وكرية دم حمراء ، وخلية دم بيضاء ، وصفيحة دموية |
| نوع من | سوائل الجسم ، ومنتج حيواني [1] |
| جزء من | جهاز الدوران |
| معرفات | |
| ترمينولوجيا أناتوميكا | 12.0.00.009 |
| FMA | 9670 |
| UBERON ID | 0000178 |
| ن.ف.م.ط. | D001769 |
بعيدًا عن تلك الخلايا نفسها.[2] يتكون من خلايا الدم الحمراء وخلايا الدم البيضاء والبلازما والصفائح الدموية، وهو عبارة عن نسيج ضام، ودرجة حرارته الطبيعية هي 37 درجة مئوية.[3][4][5]
يشكل الدم 8% من كتلة الجسم. فإذا كانت كتلة شخص ما 60 كغم مثلاً، فإن 4.8 كغم منها دم (أي نحو 5 لتر).
في الفقاريات، يتكون أغلب الدم من البلازما والتي تشكل 55٪ من سوائل الدم، تتكون البلازما في الغالب من الماء والذي يشكل 90٪ من حجمها،[6] كما تحتوي على البروتينات والجلوكوز والأيونات المعدنية والهرمونات وثاني أكسيد الكربون والبلازما هي الوسيلة الرئيسية لنقل منتجات الإخراج، الألبومين هو البروتين الرئيسي في البلازما، ويعمل على تنظيم ضغط الدم الأسموزي الغرواني، تتكون خلايا الدم بشكل أساسي من خلايا الدم الحمراء، وخلايا الدم البيضاء أو الكريات البيض والصفائح الدموية.
تحتوي خلايا الدم على الهيموغلوبين، وهو بروتين يحتوي على الحديد، مما يسهل نقل الأكسجين عن طريق الارتباط العكسي بالغازات من خلال عملية تنفس الكائنات وزيادة قابليته للذوبان في الدم بشكل كبير. في المقابل، يتم نقل ثاني أكسيد الكربون في الغالب خارج الخلية مثل البيكربونات المنقولة في البلازما.
يدور الدم في جميع أنحاء الجسم عبر الأوعية الدموية عن طريق ضخ القلب. في الكائنات ذات الرئتين، يَحمل الدم الشرياني الأكسجين من الهواء المستنشق إلى أنسجة الجسم، وينقل الدم الوريدي ثاني أكسيد الكربون، وهو فضلات ناتجة عن العملية الأيضية الذي تنتجه الخلايا، من الأنسجة إلى الرئتين لتتم عملية الزفير.
الوظيفة
يملك الدم العديد من الوظائف المهمة:[7]
- الدفاع عن الجسم: وذلك عن طريق إنتاج مُضادات الأجسام التي تُحارب الجراثيم، وتتخلص من الميكروبات المُهاجمة، والتي تتسبب في الإصابة بالعديد من الأمراض.
- التوازن المائي في الجسم: يحفظ الدم توازن الماء في الجسم، وذلك بنقل الماء الزائد من الجهاز الهضمية، أو التخلص منه من خلال الجلد على هيئة عرق، أو من خلال الكليتين على صورة بول.
- تنظيم حرارة الجسم: من خلال إفراز العرق لترطيب الجلد، أو من خلال زيادة حرق السكر في الدم من أجل توليد الطاقة، ورفع درجة حرارة الجسم.
- ايصال الأكسجين للخلايا.
- توفير العناصر الغذائية مثل الجلوكوز والأحماض الأمينية والأحماض الدهنية.
- إزالة المخلفات مثل ثاني أكسيد الكربون واليوريا وحمض اللبنيك
- إيقاف النزيف بواسطة الصفائح التي تسد طريق الدم بشكل مؤقت، ثم تُنتج العناصر التي تُساعد على التئام الجروح.
مكونات الدم
الثدييات
يشكّل الدم 7٪ من وزن جسم الإنسان،[8][9] بمتوسط كثافة حوالي 1060 كغم/م 3، والتي تقترب جدًا من كثافة الماء النقي البالغة 1000 كغم/م 3.[10] يبلغ متوسط حجم دم الشخص البالغ حوالي 5 لترات (أى حوالي 1.3 جالوناً) متمثلة في البلازما وعناصر أخرى.[9] يتكون الدم من نوعين من الخلايا هما خلايا الدم أو كريات الدم الحمراء (بالإنجليزية: erythrocytes) وخلايا الدم البيضاء (بالإنجليزية: leukocytes)، والصفائح الدموية، ولا تعتبر الصفائح الدموية خلايا،[11] لأنها تتكون من أجزاء مفلطحة من السيتوبلازم، ولها دور كبير في تخثر الدم. من حيث الحجم، تشكل خلايا الدم الحمراء حوالي 45٪ من حجم الدم الكلي، والبلازما تشكل حوالي 54.3٪، وكريات الدم البيضاء حوالي 0.7٪.
تنطبق قوانين ديناميكا السوائل غير النيوتونية. على الدم بكل مكوناته (البلازما والخلايا)[12]
 تجزئة دم الإنسان عن طريق الطرد المركزي: يمكن رؤية البلازما (الطبقة العلوية الصفراء) والطبقة البيضاء (الطبقة الوسطى والرقيقة كريات الدم البيضاء) وطبقة كرات الدم الحمراء (الطبقة السفلية الحمراء)
تجزئة دم الإنسان عن طريق الطرد المركزي: يمكن رؤية البلازما (الطبقة العلوية الصفراء) والطبقة البيضاء (الطبقة الوسطى والرقيقة كريات الدم البيضاء) وطبقة كرات الدم الحمراء (الطبقة السفلية الحمراء) الدورة الدموية: أحمر = مؤكسج، أزرق = غير مؤكسج
الدورة الدموية: أحمر = مؤكسج، أزرق = غير مؤكسج رسم توضيحي يصور عناصر مكونة من الدم
رسم توضيحي يصور عناصر مكونة من الدم
الخلايا

يحتوي واحد ميكروليتر من الدم على:
- حوالي من 4.7 إلى 6.1 مليون خلية دم حمراء لدى الذكور، وحوالي 4.2 إلى 5.4 مليون خلية في الإناث،[13] وتحتوي خلايا الدم الحمراء على هيموجلوبين الدم، كما توزّع خلايا الدم الحمراء الأكسجين على أنسجة الجسم المختلفة. في الثدييات عندما تنضج خلايا الدم الحمراء (تصبح هرمة) فإنها تفتقر إلى النواة والعضيات. يتم تمييز خلايا الدم الحمراء (مع خلايا الأوعية البطانية وخلايا أخرى) بالبروتينات السكرية التي تحدد أنواع الدم المختلفة. يشار إلى نسبة خلايا الدم الحمراء في الدم باسم الهيماتوكريت أو حجم الخلايا المكدسة، وعادة ما تكون حوالي 45٪ من الحجم الكلي للدم. إذا تم تجميع مساحة الأسطح لجميع خلايا الدم الحمراء المتواجدة في جسم الإنسان، فإنها ستكون أكبر بنحو 2000 مرة من السطح الخارجي للجسم.[14]
- حوالي من 4000 الي 11,000 خلية دم بيضاء،[15] خلايا الدم البيضاء هي جزء من جهاز المناعة في الجسم. تقوم كرات الدم البيضاء بتدمير وإزالة الخلايا القديمة أو الشاذة والحطام الخلوي (بقايا خلايا أو ميكروبات حطمتها الخلايا البُلْعُومية الأكولة)، فضلاً عن مهاجمة العوامل المعدية (مسببات الأمراض) والمواد الغريبة. يسمى سرطان كريات الدم البيضاء بـ اللوكيميا.
- من 500,000 إلي 200,000 صفيحة،[15] كما تسمى أيضًا الصفائح الدموية، وتشارك الصفائح في عملية تخثر الدم (تجلط الدم). يقترن بروتين الفايبرين مع الصفائح الدموية ومن ثم يتبلور ليكون شبكة تسمي السدادة الصفيحية (بالإنجليزية:Platelet plug) تعمل على الإرقاء (وقف النزيف).
خلايا الدم الحمراء
 مقالة مفصلة: خلية دم حمراء
مقالة مفصلة: خلية دم حمراء

خلايا قرصية الشكل مقعرة الوجهين، وظيفتها نقل الغازات، سطحها مقعر كي تزيد من مساحة تبادل الغازات، وتمتاز بغشاء خلوي مرن يُمكِنها من المرور حتى في أضيق الشعيرات الدموية. تنشا من النخاع الأحمر في العظام الكبيرة وتتجدد كل 120 يوم وتتكسر في الكبد والطحال وتذهب إلى العصارة الصفراوية لتشارك في محتوياتها، لونها أحمر لوجود مادة الهيموجلوبين وتتكون مادة الهيموجلوبين من بروتين وحديد، عددها تقريبا لدى الرجل البالغ 4 - 5 مليون وفي المرأة 4 - 4.5 مليون خلية لكل ملمتر مكعب، ومهمتها تقتصر على حمل غاز الأكسجين من الرئتين واستبداله بغاز ثاني أكسيد الكاربون. بناء كريات الدم الحمراء تتحكم به الكليتان عن طريق هرمون يدعى بالإريتروبويتين، ويعتمد إفراز هذا الهرمون على الضغط الجزئي للأكسجين في الدم. في الارتفاعات العالية يكون الضغط الجزئي للأكسجين منخفضاً لذا ينشط إفراز هرمون الإريتروبويتين مما يرفع تركيز كريات الدم الحمراء لدى سكان المناطق الجبيلة. خلية الدم الحمراء غير ناضجة تحتوي على النواة والميتوكندريا واجسام جولجي والرايبوسومات وتنمو هذه الخلايا وتنقسم انقسام متساوي حتى تعطي خلية الدم الحمراء الناضجة بعد ان تفقد النواة والعضيات الأخرى كي تجعل أكبر مساحة ممكنة لصبغة الهيموغلوبين.[16][17][18]
الخلايا البيضاء
 مقالة مفصلة: خلية دم بيضاء
مقالة مفصلة: خلية دم بيضاء

كريات الدم البيضاء هي الخلايا التي تقوم بتوفير الحماية للجسم من الأمراض وعددها اقل من خلايا الدم الحمراء إذ انه بين سبعمائة وأربعة عشر كرية حمراء نجد كرية بيضاء واحدة كما أنها متفاوتة الأحجام والاشكال وبها نواة واحدة كما أنها أكبر من خلايا الدم الحمراء. يتراوح عددها بين (5000-10000) خلية في الملمتر مكعب. وتعتبر احدى أهم وسائل الدفاع عن الأنتيجينات (مولدات الضد) في الجسم ويزداد عددها عند الإصابة بالأمراض.[19][20][21]
هناك 5 انواع من خلايا الدم البيضاء, هي: الحمضية والقاعدية والمتعادلة والليمفية والوحيدة.[22]
وتم تقسيمها حسب مظهر السيتوبلازم وشكل النواة إلى مجموعتين:
- الخلايا المحببة: وتكون كبيرة والسيتوبلازم محبب ونواتها تتكون من عدة فصوص، وتختلف هذه الخلايا في تقبلها للصبغات وتشمل المتعادلة والحمضية والقاعدية.
- الخلايا غير محببة: مظهر السيتوبلازم غير محبب وأنويتها غير مقسمة إلى فصوص، وتشمل الليمفية والوحيدة.
بلازما
 مقالة مفصلة: بلازما الدم
مقالة مفصلة: بلازما الدم

هي مادة سائلة شفافة تميل إلى الاصفرار كلون التبن (القش) وتمثل البلازما الوسط السائل في الدم، ولها دور هام في نقل الماء والأملاح والعناصر الغذائية الذائبة، مثل الجلوكوز والأحماض الأمينية والأحماض الدهنية (المذابة في الدم أو المرتبطة ببروتينات البلازما)، كما تزيل الفضلات، مثل ثاني أكسيد الكربون واليوريا وحمض اللاكتيك، كما تقوم البلازما أيضاً بتدوير الهرمونات التي تنقل رسائلها إلى أنسجة الجسم المختلفة.[23] حوالي 55٪ من الدم عبارة عن بلازما الدم.[24] يبلغ إجمالي حجم بلازما الدم 2.7 - 3.0 لتر (2.8 - 3.2 لتر) في الإنسان السوي. وهي في الأساس عبارة عن محلول مائي يحتوي على 90٪ ماء (للماء دور كبير حيث يحافظ على درجة حرارة الجسم 37 درجة مئوية) و 8٪ بروتينات بلازما الدم[25] وكميات ضئيلة من مواد أخرى ذائبة 2٪ تقريباً (أيونات الأملاح المعدنية- البروتينات - الكربوهيدرات - الدهون - الفيتامينات - أجسام مضادة - هرمونات - غازات مذابة).[23]
ومن مكونات الدم الهامة الأخرى:
- مصل الألبومين
- عوامل تخثر الدم (لتسهيل التخثر)
- الغلوبولين المناعي (الأجسام المضادة)
- جزيئات البروتين الدهني
- بروتينات أخرى مختلفة
- شوارد مختلفة (بشكل رئيسي شوارد الصوديوم والكلوريد)
يشير مصطلح "مصل الدم' إلى البلازما التي أزيلت منها بروتينات التخثر، وتكون معظم البروتينات المتبقية هي الألبومين والأجسام المضادة.
الصفائح الدموية
 مقالة مفصلة: صفيحة دموية
مقالة مفصلة: صفيحة دموية

أجسام سيتوبلازمية توجد في الدم وتتكسر عند ملامستها للهواء لتجلط الدم حتى لا يتسبب النزيف بضرر

ليس لها شكل محدد، لا تنزلق انزلاقا طبيعا في الدم مادامت سرعة الدم ثابتة وتوجد في الشخص الطبيعى بنسبة ربع مليون لكل مليمتر مكعب، دورها الأساسي هو تحويل المادة البروتينية السائلة الموجودة في الدم وهي الفبيرونجين إلى مادة صلبة تسمى الفبيرين وخيوط متصلبة تتجمع حول السطح الجلدى لتمنع خروج الدم من الجلد.[26] لا يتجلط الدم داخل الاوعية الدموية؛ لان الدم يسرى بصورة طبيعية وأيضاً لوجود مادة الهيبارين التي يفرزها الكبد والتي توقف عمل الصفائح الدموية وللعلم فان الصفائح الدموية تتكسر من الكبد والطحال كل 10ايام لتتجدد باستمرار ويمكن القول بانها اجسام غير خلوية لانها تتكسر باستمرار.[27][28][29]
قيم الأس الهيدروجيني
 مقالة مفصلة: استتباب حمضي قاعدي
مقالة مفصلة: استتباب حمضي قاعدي
يتم تنظيم درجة حموضة الدم لتبقي ضمن النطاق الضيق من 7.35 إلى 7.45 pH، مما يجعل الدم قلوي ضعيف.[30][31] ويعتبر الدم الذي يحتوي على درجة حموضة أقل من 7.35 حمضياً جداً، في حين عندما ترتفع قيمة pH الدم لأعلى من 7.45 فإنه يعتبر قاعدي جداً. يتم تنظيم بعناية درجة حموضة الدم، والضغط الجزئي للأكسجين (pO2)، والضغط الجزئي لثاني أكسيد الكربون (pCO2)، والبيكربونات (HCO3−) بواسطة عدد من آليات الاستتباب (التوازن) الداخلي للجسم، والتي تمارس تأثيرها بشكل أساسي من خلال الجهاز التنفسي والجهاز البولي للسيطرة على التوازن الحمضي-القاعدي والتنفس. يقيس اختبار غازات الدم الشرياني توتر ثاني أكسيد الكربون والتوتر الشرياني الأوكسجيني وقيمة pH. وتلك قائمة النطاقات المرجعية الطبيعية للعديد من إلكتروليتات الدم واسعة النطاق.[32]
في الفقاريات غير الثديية
يعتبر دم الإنسان نموذجي مقارنة بدم باقي الثدييات، على الرغم من أن التفاصيل الدقيقة المتعلقة بأعداد الخلايا وحجمها وبنيتها البروتينية وما إلى ذلك تختلف إلى حد ما من فصيلة لأخرى. ومع ذلك، فهناك بعض الاختلافات الرئيسية في الفقاريات غير الثديية:[33]
- تتخذ خلايا الدم الحمراء في الفقاريات غير الثديية شكلاً مفلطحاً وبيضوياً، وتحتفظ بنواة داخل خلاياها.
- هناك تباين كبير في أنواع ونسب خلايا الدم البيضاء. على سبيل المثال، توجد أعداد أكبر من خلايا الأسيدوفيل (بالإنجليزية:Acidophil cell) بشكل عام في الفقاريات غير الثديية وأكثر شيوعًا من البشر.
- توجد الصفائح الدموية في الثدييات فقط، بينما في الفقاريات الأخرى فإن الخلايا المغزلية الصغيرة أحادية النواة والتي تسمى أيضاً الصفيحات هي المسؤولة عن تخثر الدم بدلاً من ذلك.
علم وظائف الأعضاء (فسيولوجي)
نظام القلب والأوعية الدموية
 مقالة مفصلة: جهاز الدوران
مقالة مفصلة: جهاز الدوران

يدور الدم في جميع أنحاء الجسم عبر الأوعية الدموية عن طريق ضخ القلب له في نظام مغلق، والقلب عبارة عن مضخة مزدوجة ماصة وكابسة، بحيث يؤخذ الدم من بعض الأوعية الدموية ويتم الدفع به في أوعية دموية أخرى. في البشر يُضخ الدم من البطين الأيسر للقلب عبر الشرايين ومنها إلى الأنسجة الطرفية ومن ثم يعود إلى الأذين الأيمن للقلب عبر الأوردة. ثم يدخل الدم إلى البطين الأيمن ويتم ضخه عبر الشريان الرئوي إلى الرئتين ليعود إلى الأذين الأيسر عبر الأوردة الرئوية. ثم يدخل الدم إلى البطين الأيسر ليبدأ دورة أخرى. يحمل الدم الشرياني الأكسجين (الدم المؤكسج) من الهواء المستنشق إلى جميع خلايا الجسم، وينقل الدم الوريدي (غير المؤكسج) ثاني أكسيد الكربون الذي يعتبر نفايات ناتجة عن عملية التمثيل الغذائي لخلايا الجسم، إلى الرئتين لتتم عملية الزفير. بشكل عام فإن جميع الشرايين تحمل دماً مؤكسجا (نقي) ومع ذلك، هناك استثناء واحد وهو الشريان الرئوي الخارج من إلى الرئتين، والتي تحتوي على أغلب الدم غير المؤكسج في الجسم، بينما تحتوي الأوردة الرئوية على الدم المؤكسج.[34][35][36]
قد ينتج تدفق عائد إضافي بسبب حركة العضلات الهيكلية، والتي يمكن أن تضغط على الأوردة وتدفع الدم عبر الصمامات في الأوردة بإتجاه الأذين الأيمن.
وقد تم وصف الدورة الدموية بواسطة ويليام هارفي في عام 1628.[37]
إنتاج وتحلل خلايا الدم

في الفقاريات، تُصنع خلايا الدم المختلفة في نخاع العظام بحيث تكون جميع الخلايا في صورتها الأولية وهي الخلايا الجذعية، وتسمى تلك العملية "عملية تكوين الدم"، والتي تشمل تكوين وإنتاج خلايا الدم الحمراء، إنتاج خلايا الدم البيضاء بأنواعها والصفائح الدموية.[39][40] تُنتج كل عظام البشر تقريبًا خلايا الدم الحمراء، وذلك أثناء مرحلة الطفولة، وبالنسبة للبالغين، فإن إنتاج خلايا الدم الحمراء على يقتصر على العظام الطويلة مثل عظام الصدر (عظمة القص) وعظام القفص الصدري وعظام الحوض وعظام الذراعين والساقين. بالإضافة إلى ذلك، تعتبر الغدة الصنوبرية، الموجودة في المنصف، مصدراً هاماً لإنتاج الخلايا اللمفاوية التائية.[41] وغالباً ما يتم إنتاج المكونات البروتينية للدم (بما في ذلك بروتينات التخثر) عن طريق الكبد، بينما يتم إنتاج الهرمونات بواسطة الغدد الصماء ويتم تنظيم الجزء المائي لخلايا الدم بواسطة منطقة ما تحت المهاد والتي تحافظ عليه الكلى.
تتمتع كريات الدم الحمراء السليمة بعمر يبلغ حوالي 120 يومًا وذلك قبل أن تتحلل إلى مكوناتها الأساسية بواسطة الطحال وخلايا كوبفر (خلايا بلعمية متخصصة توجد في الكبد وتبطن جدران جيب الكبد).[42][43]
عملية نقل الأكسجين

يتم إرتباط حوالي 98.5٪ من الأكسجين كيميائياً مع الهيموجلوبين[44] وذلك عند فحص عينة من الدم الشرياني (المؤكسد) لدى إنسان ليست لديه أي مشاكل صحية تنفسية، وذلك عند ضغط يساوي ضغط مستوي سطح البحر. تذوب حوالي 1.5٪ من نسبة الأكسجين المتبقية فيزيائيًا في سوائل الدم الأخرى ولا ترتبط بالهيموجلوبين.[45] يعتبر جزيء الهيموجلوبين هو الناقل الأساسي للأكسجين في الثدييات والعديد من الفصائل الأخرى (للاستثناءات، انظر أدناه). يمتلك جزئ الهيموجلوبين القدرة على الارتباط بالأكسجين بسعة ما بين 1.36 و 1.40 مل من O2 لكل جرام من الهيموجلوبين، مما يزيد من سعة الأكسجين الإجمالية في الدم سبعين ضعفًا،[46] وبالمقارنة إذا ما كان الأكسجين يُحمل فقط من خلال قابليته للذوبان البالغة 0.03 مل من O2 /لكل لتر من الدم/ لكل مم من الزئبق للضغط الجزئي الأكسجين (حوالي 100 ملم زئبق في الشرايين).[46]
باستثناء الشرايين الرئوية والسرية والأوردة المقابلة لها، تَحمِل الشرايين الدم المؤكسج بعيدًا عن القلب وتوصله إلى الجسم عبر الشرايين والشعيرات الدموية، وهناك حيث يتم استهلاك الأكسجين، ومن ثم بعد ذلك تقوم الأوردة بنقل الدم غير المؤكسج إلى القلب.
تحت المعدلات الطبيعية عند البالغين وفي حالة الراحة، يكون الهيموجلوبين الذي يغادر الرئتين مشبعًا بالأكسجين بنسبة تصل إلى 98-99٪، مما يؤدي إلى وصول الأكسجين إلى الجسم بمعدل يصل إلى ما بين 950 و 1150 مل / دقيقة.[47] يتم استهلاك الأكسجين تقريبًا بمعدل 200-250 مل / دقيقة،[47] في البالغين الأصحاء في حالة الراحة، بحيث يظل الدم غير المؤكسج العائد إلى الرئتين مشبعًا بنسبة 75 ٪ [48][49]من الأكسجين (70 ٪ إلى 78 ٪).[47] تؤدي زيادة استهلاك الأكسجين أثناء التمارين المستمرة إلى تقليل تشبع الأكسجين في الدم الوريدي، والذي يمكن أن يصل إلى نسبة أقل من 15٪ في الرياضيين المُدرَبين؛ لكن بالرغم من ذلك فإن معدل التنفس وتدفق الدم يزداد لتعويض ذلك النقص، يمكن أن ينخفض تشبع الأكسجين في الدم الشرياني إلى 95٪ أو أقل في ظل هذه الظروف.[50] إذا ما تشبع الأكسجين بهذا المستوى، فإن ذلك يعتبر مؤشراً خطيراً على صحة الفرد أثناء فترات الراحة (على سبيل المثال، أثناء الجراحة الحادثة تحت التخدير). ويعتبر نقص الأكسجة المستمر (أكسجة أقل من 90٪) خطر على الصحة، ومن الممكن أن يتسبب في الموت السريع إذا نقصت الأكسجة بشدة (التشبع أقل من 30٪).[51]
تقوم الأجنة الحية بإنتاج شكلاً أخر من أشكال الهيموغلوبين متقارب بشكل أكبر مع الأكسجين وهو "الهيموغلوبين F"؛ وذلك لتعرض الجنين لنسبة أكسجين منخفضة جداً (حوالي 21٪ من مستوى الأكسجين الموجود في رئة شخص بالغ)، لتلاقيه الأكسجين عن طريق المشيمة فقط.[52]
عملية نقل ثاني أكسيد الكربون

ينتقل ثاني أكسيد الكربون في الدم بثلاث طرق مختلفة (تختلف النسب الدقيقة حسب ما إذا كان الدم ينتقل عبر الشرايين أو الأوردة). يتم تحويل معظم ثاني أكسيد الكربون (حوالي 70٪) إلى أيونات بيكربونات HCO3 بواسطة إنزيم الأنهيدراز الكربوني في خلايا الدم الحمراء عن طريق التفاعل التالي:
يرتبط ما يصل إلى 23٪ من الهيموجلوبين كمركبات كربامينو مكوناً "كَرْبامينوهيمُوغلوبين"،[53] ويذوب حوالي 7٪ في البلازما.[54][55]
الهيموجلوبين هو الجزئ الرئيسي الحامل للأكسجين في خلايا الدم الحمراء، حيث يحمل كل من الأكسجين وثاني أكسيد الكربون.[56] ومع ذلك، فإن موقع إرتباط ثاني أكسيد الكربون مع الهيموجلوبين مختلف عن موقع ارتباطه بالأكسجين، فبدلاً من ذلك فإن يتحد مع مجموعات الطرف الأميني-N على سلاسل البروتينات الكُريوية (الغلوبينات).[57] ومع ذلك، نظرًا للتأثيرات التفارغية على جزيء الهيموجلوبين، فإن ارتباط ثاني أكسيد الكربون يقلل من كمية الأكسجين المرتبطة بضغط جزئي معين من الأكسجين. يُعرف انخفاض الارتباط بثاني أكسيد الكربون في الدم بسبب زيادة مستويات الأكسجين بـ "تأثير هولدين"، والذي يعتبر صفة مميزة الهيموغلوبين، حيث يعمل نزع الأكسجين من الدم إلى زيادة حمل ثاني أكسيد الكربون، بالمقابل فإن الدم المؤكسج له قابلية منخفضة على حمل ثاني أكسيد الكربون.[58]
نقل أيونات الهيدروجين
تفقد جزيئات الأوكسيهيموجلوبين بعض من جزيئات الأكسجين لتتحول إلى ثاني أكسيد الهيموجلوبين. ترتبط مُعظم أيونات الهيدروجين بجزئ الدي أوكسيهيموجلوبين لإنجذابه للهيدروجين أكثر من الأوكسي هيموجلوبين.
الجهاز اللمفي
 مقالة مفصلة: جهاز لمفي
مقالة مفصلة: جهاز لمفي
يكون الدم في حالة توازن مع اللمف في معظم الثدييات، ويتشكل اللمف باستمرار في أنسجة الدم عن طريق الترشيح الفائق الشعري. يتم جمع اللمف بواسطة نظام من الأوعية اللمفاوية الصغيرة ومن ثم يتم توجيهه إلى القناة الصدرية، والتي تصب في الوريد تحت الترقوة الأيسر، وهناك حيث ينضم اللمف إلى الدورة الدموية.[59][60]
التنظيم الحراري
 مقالة مفصلة: تنظيم حراري
مقالة مفصلة: تنظيم حراري

تقوم الدورة الدموية بدور آخر غير نقل الدم، ألا وهو نقل الحرارة في جميع أنحاء الجسم، وتعد التعديلات على هذا التدفق جزءًا مهمًا من التنظيم الحراري. فعلى سبيل المثال عندما يكون الطقس دافئ أو أثناء القيام بالتمارين الشاقة، فإن معدل تدفق الدم يزداد ما يتسبب في دفء الجلد، مما يؤدي إلى فقدان الحرارة بشكل أسرع. وفي المقابل، عندما تكون درجة الحرارة الخارجية منخفضة، ينخفض تدفق الدم إلى الأطراف وسطح الجلد، ولمنع فقدان الحرارة يتم توزيع الدم بشكل تفضيلي على أعضاء الجسم المهمة.[62][63][64]
معدل تدفق الدم
 مقالة مفصلة: تدفق الدم
مقالة مفصلة: تدفق الدم
تتفاوت معدلات تدفق الدم بشكل كبير بين أعضاء الجسم المختلفة. يحتوي الكبد على أكبر معدل لإمدادات الدم وفرة بتدفق تقريبي يصل إلى 1350 مل / دقيقة، كما تُعد الكلى والدماغ ثاني وثالث أكثر الأعضاء إمدادًا، بمعدل 1100 مل / دقيقة و 700 مل / دقيقة على التوالي.[65]
تختلف المعدلات النسبية لتدفق الدم لكل 100 غرام من الأنسجة المختلفة، بحيث تكون الكلى والغدة الكظرية والغدة الدرقية هي الأنسجة الأولى والثانية والثالثة على التوالي التي تحصل على الإمداد.[65]
وظائف هيدروليكية
يمكن استخدام تدفق الدم في بعض الأنسجة المتخصصة لإحداث إحتقان؛ مما يؤدي لانتصاب تلك الأنسجة، ومن الأمثلة على ذلك انتصاب نسيج كل من القضيب والبظر.
العنكبوت القافز، هو مثال آخر على الوظيفة الهيدروليكية للدم، بحيث يتم دفع الدم إلى السيقان الواقع عليها ضغط جسد العنكبوت مما يؤدي لإستقامتها لإحداث قفزة قوية، دون الحاجة لوجود أي عضلات في سيقانه.[66]
لافقاريات

لا يشارك هيمولمف الحشرات (أو اللمف الدموى، دم الحشرات) في عملية نقل الأكسجين، حيث تتم عملية التنفس عن طريق فتحات تسمى القصبة الهوائية تسمح للأكسجين من الهواء بالانتشار مباشرة إلى الأنسجة. يعمل دم الحشرات علي نقل المغذيات إلى الأنسجة وإزالة الفضلات في نظام مفتوح.[67]
تستخدم اللافقاريات الأخرى بروتينات الجهاز التنفسي لزيادة القدرة على حمل الأكسجين، ويُعد الهيموغلوبين البروتين الأكثر شيوعًا في الطبيعة. يحتوي الهيموسيانين (الأزرق) على النحاس ويوجد في كل من القشريات والرخويات. ويُعتقد أن الغلاليات (بخاخات البحر) تستخدم الفانابينات (بروتينات تحتوي على الفاناديوم) لصبغة جهازها التنفسي (أخضر فاتح أو أزرق أو برتقالي).[68]
تكون البروتينات الحاملة للأكسجين قابلة للذوبان في الدم بحرية في أغلب اللافقاريات. بينما في الفقاريات توجد في خلايا الدم الحمراء المتخصصة، مما يسمح بتركيز أعلى من أصباغ الجهاز التنفسي دون زيادة لزوجة الدم أو إتلاف أعضاء ترشيح الدم مثل الكلى.
لدى الديدان الأنبوبية الكبيرة هيموجلوبين غير عادي والذي يسمح لهم بالعيش في البيئات غير الاعتيادية، كما قد يحتوي الهيموجلوبين علي كبريتيدات والتي ما تكون قاتلة في الحيوانات الأخرى.
فصائل الدم
 مقالة مفصلة: فئات الدم
مقالة مفصلة: فئات الدم

كان الاعتقاد السائد قبل بدايات القرن العشرين أن الدم يتكون من نوع واحد فقط متماثل بين جميع البشر وغالباً ما كانت محاولات نقل الدم من الأشخاص السليمين للمرضى تؤدي إلى موت المرضى الأمر الذي أدى إلى منع نقل الدم لفترات طويلة في أوروبا حتى قام العالم النمساوي كارل لاندشتاينر باكتشاف ما يسمى الانتجينات في الدم عام 1902، عندما لاحظ وفاة بعض المرضى عند نقل الدم، والانتجينات عبارة عن بروتينات سكرية موجودة على سطح خلية الدم الحمراء، وتم تقسيم فصائل الدم لاحقا إلى أربع أنواع هي A وB وAB وO يتم تحديد زمرة الدم جينيا ً حيث يوجد لدى الإنسان نوعين من المورثات نوع A ونوع B وعند وجود كلا النوعين A وB لدى الحمض النووي لهذا الشخص تكون زمرة دمه AB إما إذا وجدت المورثة A فقط فزمرة دمه هي A وبذات الطريقة بالنسبة لزمرة الدم B أما عند عدم وجود أي من هاتين المورثتين تكون زمرة الدم O. وهناك فصيلة نادرة جدا من الدم وهي الدم الذهبي وهو OH ويقدر وجوده ب1 أو 3 أشخاص في المليون وسجلت السعودية 3 أشخاص يمتلكونه أما أمريكا الجنوبية فسجلت 7 أشخاص فقط وهناك وقد تم إستكشافه في [مومباي] ولذلك يسمى فصيلة دم مومباي أيضا. العامل الرايزيسي RH حيث أن هناك نوع آخر من البروتينات السكرية (الأنتجين) على سطح خلية الدم الحمراء، وسمي بهذا الاسم نسبة إلى القرد الرايزيسي لأنه يحمل هذا العامل، ويلحق بكل نوع من هذه الأنواع إشارة موجب (+) أو سالب (-) حيث ترمز إشارة (+) إلى وجود بروتين إضافي رمزه RH والإشارة (-) ترمز إلى عدم وجود هذا البروتين والزمر الدموية الموجبة أكثر انتشاراً بسبب كونها صفة وراثية سائدة.[69][70][71]
يبين الجدول التالي إمكانية نقل الدم من عدمه بين الفصائل الدموية المختلفة.[72][73]
| آخذ / معطي | AB+ | AB- | A+ | A- | B+ | B- | O+ | O- |
|---|---|---|---|---|---|---|---|---|
| AB+ | ||||||||
| AB- | ||||||||
| A+ | ||||||||
| A- | ||||||||
| B+ | ||||||||
| B- | ||||||||
| O+ | ||||||||
| O- |
اللون
الهيموجلوبين
 مقالة مفصلة: هيموغلوبين
مقالة مفصلة: هيموغلوبين

الهيموجلوبين هو العامل الأساسى في الفقاريات الذي يعطي الدم لونه الأحمر. يحتوي كل جزئ هيموجلوبين على أربعة مجموعات من الهيم وهو الصباغ الذي يعطي الدم لونه الأحمر لاحتوائه على ذرة الحديد. يكون لون الدم أحمر فاتح عندما يمر الدم عبر الشرايين والشعيرات الدموية حيث يضفي الأكسجين لوناً أحمراً قوياً علي مجموعة الهيم، وذلك في الفقاريات والكائنات الأخرى التي تستخدم الهيموجلوبين. يكون لون الدم أحمر غامق عندما يكون غير مؤكسج ويتواجد هذا الدم في الأوردة، ويمكن رؤيته أثناء التبرع بالدم أو عند أخذ عينات الدم الوريدي. ويرجع ذلك إلي اختلاف طيف الهيدروجين المُمتص بين حالتي الأكسدة واللاأكسدة.[74]
تظهر الأوردة القريبة من سطح الجلد بالون الأزرق لعدة أسباب، والعوامل المساهمة في تغيير إدراك لون الدم ليظهر بالون الأزرق بدلاً من اللون الفعلي للدم الوريدي تكون مرتبطة بخصائص تشتت الضوء للجلد ومعالجة المدخلات بواسطة القشرة البصرية.[75]
تظهر دماء السقنقورية (أحد فصائل البراسينو هيما) باللون الأخضر، وذلك بسبب تراكم نفايات البيليفردين.[76]
الهيموساينين
 مقالة مفصلة: هيموسيانين
مقالة مفصلة: هيموسيانين

يتلون دم معظم الرخويات باللون الأزرق بما في ذلك رأسيات الأرجل وبطنيات الأقدام، كذلك بعض المفصليات مثل سرطان حدوة الحصان، وذلك لاحتواء الدم على بروتين الهيموسيانين المحتوي على النحاس بتركيز حوالي 50 جرام لكل لتر.[77] يصبح الهيموسيانين عديم اللون عند إزالة الأكسجين ويتلون باللون الأزرق الداكن عند أكسدته. يتحول الدم في الدورة الدموية للمخلوقات التي تعيش عمومًا في بيئات باردة مع توتر منخفض للأكسجين إلى اللون الرمادي والأبيض إلى الأصفر الباهت،[77] ويتحول إلى اللون الأزرق الداكن عند تعرضه للأكسجين في الهواء ويظهر ذلك عند حدوث النزيف بسبب تغير لون الهيموسيانين عندما يتأكسد.[77] يحمل الهيموسيانين الأكسجين في السائل الخارجي للخلية، على النقيض من نقل الأكسجين داخل الخلايا في الثدييات عن طريق الهيموجلوبين في كرات الدم الحمراء.[77]
الكلوروكرورين

تستخدم معظم الديدان الحلقية وبعض الديدان متعددة الأشواك البحرية بروتين الكلوروكورين لنقل الأكسجين. وهو عبارة عن بروتين أخضر اللون في المحاليل المخففة.[78]
فحص الدم ونتائجه

هو إجراء طبي لا غنى عنه لتشخيص الحالة الصحية للإنسان ولتشخيص الكثير من الأمراض. يمكن استنتاج معلومات عن صحة الفرد وعاداته من نقطة واحدة من الدم كالآتي:[81][82][83][84]
- التغذية: من يأكل لحوما كثيرا يزداد لديه الكولسترول ولكن لا يكون لازما أن يكون مستوى الكولسترول في الدم حرجا. والمهم هو نسبة الكولسترول الحسن إلى الكولسترول السيء. الكولسترول الحسن ينقي جدران الأوعية الدموية من المسببات التكلس ويذهب بها إلى الكبد للتخلص منها.[85]
- العمر: في أطراف الكروموسومات المأخودة من خلايا الدم توجد تيلوميرات تحافظ عليها. تلك التيلوميرات ينقص طولها بالتقدم في العمر (تقصر بتعدد الانقسامات الخلوية). وهي بذلك وسيلة لمعرفة عمر الشخص البيولوجي.
- الفيروسات: كثير من الفحوص لا تبين وجود فيروسات في الدم مباشرة. عندئذ يتم الفحص عن مضادات الفيروسات في الدم، وهي التي يكونها نظام المناعة لمقاومة الفيروس.
- اللياقة البدنية: بتعيين تركيز لاكتات الناتجة من التمثيل الغذائي في الدم يمكن استنباط اللياقة البدنية للشخص. عداء الماراثون مثلا يكون معدل اللاكتات في دمهم أقل من معدله في غير الرياضيين.
- الحمل : بعد أيام قليلة من بعد تخصب البويضة يبدأ هرمون موجهة الغدد التناسلية المشيمائية في الظهور في الدم. وهو يظهر أيضا في البول ولكن بعد أسبوعين. إلا أنه في أحوال نادرة يمكن أن يكون ورم هو المتسبب هو في نسبة عالية من هذا الهرمون في الدم.
- الفصيلة الدموية: توجد أربعة فصائل للدم، يتبع كل فرد فصيلة منها . تلك الفصائل هي: A , B , AB, O وتميزها أنواع معينة من البروتينات التي تغطي كرات الدم الحمراء ؛ وتلك البروتينات لا توجد في فصيلة O للدم.
- الكحوليات: كثرة شرب الكحوليات يفسد الدم . ينخفض عدد كرات الدم البيضاء بسببه . كما تدمر الخمور جزء من كرات الدم الحمراء وتكبر في حجمها. وتقاس تلك التغيرات عن طريق تعيين القيمة MCV .
- الروماتيزم: تعرف المناعة الذاتية عندما يقوم جهاز المناعة بمقاومة خلايا الجسم السليمة نفسها . وفي الأشخاص الذين لديهم تلك الخاصية يوجد في دمهم ضد يسمى ANA.
- الغدة الدرقية: الأشخاص الذين يتعبون سريعا وتنخفض لديهم القدرة على التركيز قد يكونوا يعانون من فقر في وظيفة الغدة الدرقية. في تلك الحالة يظهر في الدم نسبة عالية لهرمون هرمون منبه الدرقية.[86][82]
- السرطان: ينتج عن ورم خلايا ميته، تسير في الدورة الدموية. ويوجد طرق لفحصها في الدم. ويمكن عن طريق معرفة تغييراتها الجينية معرفة نوع السرطان المتسبب.[82]
- الكرب: في حالة الكرب يزداد افراز الجسم لهرمون الكورتيزون، الذي يمكن تعيينه في الدم. إلا أن قيمة الكورتيزون العالية قد تنشأ من انخفاض في نسبة السكر في الدم أو من حالة حمل.
أمراض
الطب العام
اضطرابات الحجم
- يمكن أن تسبب الإصابة حدوث النزيف المؤدي لفقدان الدم، حيث قد يفقد الشخص البالغ السوي ما يقرب من 20٪ من حجم الدم (1 لتر) قبل ظهور الأعراض الأولى عليه وبدء الأرق، و 40٪ من حجم الدم (2 لتر) قبل حدوث الصدمة. تعد الصفيحات الدموية هامة لتخثر الدم وتكوين جلطات الدم ، والتي يمكن أن توقف النزيف. كما يمكن أن تتسبب الصدمات التي تصيب الأعضاء الداخلية أو العظام في حدوث نزيف داخلي قد يكون شديدًا في بعض الأحيان.
- يمكن أن يقلل الجفاف من حجم كريات الدم عن طريق تقليل محتوى الماء في الخلية. نادرًا ما ينتج عن هذا صدمة (باستثناء الحالات الشديدة جدًا) ولكنه قد يؤدي إلى انخفاض ضغط الدم الانتصابي وفي بعض الحالات الإغماء.
اضطرابات الدورة الدموية
- يعتبر تأثير الصدمة مضاد لعملية التروية الدموية للأنسجة، ويمكن أن تنتج الصدمة عن مجموعة متنوعة من الحالات بما في ذلك فقدان الدم، والعدوى، وضعف النتاج القلبي.
- يعمل تصلب الشرايين علي خفض معدل تدفق الدم بالشرايين، لتبطن الشرايين بالعصيدة التي تعمل على تضيقها. تميل العصيدة إلى الزيادة مع تقدم العمر، ويمكن أن يتفاقم تطور التصلب الشرياني للعديد من الأسباب بما في ذلك التدخين، وارتفاع ضغط الدم، وزيادة الدهون في الدورة الدموية (فرط شحميات الدم)، وداء السكري.
- يمكن أن يشكل تخثر الدم جلطة والتي قد تسد مجرى الأوعية الدموية.
- غالباً ما يلي مشاكل تكوين الدم، وعمل ضخ القلب، أو تضييق الأوعية الدموية العديد من العواقب بما في ذلك نقص الأكسجة (نقص الأكسجين) في الأنسجة الموردة. يشير مصطلح نقص التروية إلى الأنسجة التي لا تُروى بشكل كافٍ بالدم، ويشير مصطلح الاحتشاء إلى موت الأنسجة (النخر)، والذي يمكن أن يحدث عندما يتم منع تدفق الدم (أو يكون غير كافٍ للغاية).
علم أمراض الدم
- عندما لا يحتوي الدم على خلايا دم حمراء صحية كافية لحمل المقدار الملائم من الأكسجين لأنسجة الجسم (فقر الدم)، وغالباً ما يحدث بسبب انخفاض تركيز الهيموجلوبين عن المستوى الطبيعي. قد يجعلك فقر الدم تشعر بالتعب والضعف. وتوجد عدة أنواع من فقر الدم، ولكل نوع أسبابه الخاصة. قد يكون فقر الدم مؤقت أو طويل المدى، وقد يتدرَّج من بسيط إلى شديد، وقد يكون علامةً تحذيرية على مرض خطير، أو اضطرابات الدم مثل الثلاسيميا، أو نقص التغذية، وقد تتطلب عملية نقل دم واحدة أو أكثر. ومن الممكن الإصابة فقر الدم بسبب اضطراب وراثي لا تعمل فيه خلايا الدم الحمراء بشكل فعال. يمكن تأكيد الإصابة بالأنيميا عن طريق فحص الدم إذا كانت قيمة الهيموجلوبين أقل من 13.5 جم / ديسيلتر عند الرجال أو أقل من 12.0 جم / ديسيلتر عند النساء. لدى العديد من البلدان بنوك الدم لتلبية الطلب على الدم القابل للنقل. يجب أن يكون لدى كل من الشخص الذي يتلقى الدم والمتبرع فصيلة دم متوافقة.[87][88]
اضطرابات تكاثر الخلايا
- اللوكيميا هو عبارة عن مرض خبيث يصيب جملة الخلايا المكونة للدم ويتصف بزيادة عدد كريات الدم البيضاء غير الناضجة في الدم.[89][89]
- كثرة الحمرا الحقيقة: وينتج عنها زيادة في تصنيع جميع أنواع خلايا الدم الحمراء، البيضاء غير اللمفاوية، والصفيحات. وتؤدي الإصابة إلى الزيادة في عدد الكريات الحمراء وإلى انخفاض مرافق في الإريثروبويتين.[90][91]
- متلازمة خلل التنسج النخاعي: عبارة عن نمو غير طبيعي لخلايا الدم في مرحلة التكون النخعي.[92]
اضطرابات التخثر
- الهيموفيليا هي عبارة عن مرض وراثي (أو نادرًا ما يحدث بسبب مشاكل في المناعة الذاتية للجسم)[93] يسبب المرض نقصاُ في عوامل تخثر البلازما الذي يعمل على تسوية عملية تخثر الدم، فعندما يصاب وعاء دموي بجرح لن تتكون خثرة وسيستمر الدم بالتدفق لمدة طويلة.[94]
- يمكن أن يؤدي نقص اعداد الصفائح الدموية إلى اعتلال التخثر (اضطرابات النزيف).[95]
- أهبة التخثر هو اضطراب في عملية تخثر الدم التي تؤدي إلى زيادة حدوث الخثار داخل الأوعية الدموية.[96]
إضرابات الدم الناتجة عن الإصابة بعدوى
- يعتبر الدم أحد النواقل الهامة للعدوى، كمثال ينتقل فيروس نقص المناعة البشرية HIV، وهو الفيروس المسبب لمرض الإيدز، عن طريق ملامسة الدم أو السائل المنوي أو إفرازات الجسم الأخرى للشخص المصاب. ينتقل التهاب الكبد B وC بشكل أساسي من خلال ملامسة الدم. عادة ما يتم التعامل مع الأشياء الملطخة بالدم على أنها خطرة بيولوجية؛ بسبب قدرة العدوى والأمراض على الانتقال عن طريق الدم.
التسمم بأول أكسيد الكربون
 مقالة مفصلة: تسمم بأحادي أكسيد الكربون
مقالة مفصلة: تسمم بأحادي أكسيد الكربون
.jpg.webp)
يمكن لبعض المواد الأخرى غير الأكسجين أن ترتبط بالهيموجلوبين، والذى من الممكن أن يسبب ضررًا لا يمكن إصلاحه للجسم. على سبيل المثال يعتبر أول أكسيد الكربون خطير للغاية عند إنتقاله إلى الدم بواسطة الرئتين نتيجة لعملية الاستنشاق، وذلك لأن أول أكسيد الكربون يرتبط بشكل لا رجعة فيه بالهيموغلوبين مكونا الكربوكسي هيموغلوبين، بحيث يكون الهيموجلوبين أقل حرية في إرتباطه مع الأكسجين، ونتيجة لذلك فإن ما ينتقل من جزيئات الأكسجين عبر الدم يقل تدريجيا. تكمن الخطورة أن غاز أحادي أكسيد الكربون غاز عديم اللون والرائحة، مما يصعب من مهمة التحقق من وجوده. يتشكل أحادي أكسيد الكربون من الاحتراق غير الكامل للمواد العضوية نتيجة عدم توفر كميات كافية من الأكسجين لتسمح بحدوث احتراق كامل والتحول إلى غاز ثنائي أكسيد الكربون CO2، كما يمكن أن ترتبط بعض من جزيئات أول أكسيد الكربون بالهيموجلوبين عند تدخين التبغ.[97][98][99]
المُعالجة بإستخدام الدم
ناتج الدم

يتم تجميع الدم المستخدم في عمليات نقل الدم من قبل متبرعين ومن ثم يتم حفظه في بنوك الدم. توجد عدة أنواع مختلفة من الدم لدى البشر، وتعد أشهر مجموعتين هما نظام مجوعة ABO ونظام الزمرة الدموية الريسوسية. عند تزويد المريض بعينة دم غير متكافئة مع زمرة دمه من الممكن أن تحدث له مضاعفات قد تكون خطيرة أو احياناُ تصل لحد الموت، لذلك يتم عمل اختبار لمعرفة إذا ماكانت الزمرتان متوافقتان لضمان سلامة عملية النقل. عادة ما يتم الكشف عن الدم الناتج من عملية التبرع بعد تجميعة، لجعله مناسب لإستخدامات المرضى. يتم فصل الدم بعد ذلك لمكوناته بواسطة الطرد المركزي لينتج: خلايا دم حمراء، خلايا دم بيضاء، وبلازما، وصفائح دموية، وبروتين الألبيومين، وعوامل تخثر الدم، والراسب المبرد (Cryoprecipitate) والذي يحضر من بلازما الدم المجمدة، الأجسام المضادة، والفيبرينوجين المركز.[100][101]
المعالجة عن طريق الوريد
 مقالة مفصلة: معالجة وريدية
مقالة مفصلة: معالجة وريدية
تُعطى العديد من الأدوية (بدأ من المضادات الحيوية إلي العلاج الكيميائي) عن طريق الأوردة، وذلك لصعوبة إمتصاصها من قبل الجهاز الهضمي.
عند حدوث فقدان حاد في الدماء، يمكن أن يتم إعطاء المريض بعض السوائل والتي تعرف "بموسعات البلازما" والتي يتم حقنها وريدياُ إما في صورة محاليل ملحية (كلوريد الصوديوم، كلوريد البوتاسيوم، كلوريد الكالسيوم...إلخ) وذلك في حالة التركيزات الفسيولجية، أو في صورة محاليل غروية مثل الديكستران، مصل الألبيومين، أو بلازما حديثة متجمدة. يعتبر استخدام موسعات البلازما في مثل تلك الحالات إجراء أكثر فاعلية من نقل الدم، وذلك لأن الدم المنقول لا يتم تمثيلة غذائياُ مباشرة بعد نقل الدم.[102]
الإدماء
 مقالة مفصلة: فصد
مقالة مفصلة: فصد
يعد الفصد أحد أساليب المعالجة الطبية القديمة والذي كان يعتقد أن الدم وجميع سوائل البلازما الأخرى يجب أن تبقي في حالة توازن مناسبة بهدف الحفاظ على صحة المريض، ويتم القيام بعملية الإدماء عن طريق سحب الدماء من المريض لمنع أو علاج الأمراض، ولقد تخلى الأسلوب الطبي الحديث عن جميع هذه الممارسات باستثناء بعض الحالات الطبية الخاصة.[103][104] ظل أستخدام تلك الطريقة شائعاً في أوربا نسبياُ حتى أواخر القرن الثامن عشر.[105]
قابلية التطبيق العلمي
العلوم التطبيقية

يمكن لبقايا الدم أن تساعد الأطباء الذين يعملون في الطب الشرعي أو علم الأدلة الجائية في تحديد نوع الأسلحة، وإعادة بناء الإجراءات الجنائية، وربط المشتبه بهم بالجريمة، وذلك لأن من الصعب إزالة بقاياه بصورةٍ كاملة، وقد تم استعادة بقايا الدم من أدواتٍ حجريةٍ يبلغ.[106] من خلال تحليل نمط بقع الدم، يمكن أيضًا الحصول على معلومات الطب الشرعي من التوزيع المكاني لبقع الدم وتحليل بقايا الدم هو أيضًا تقنية تستخدم في علم الآثار.
عادةً يُفَتَش مسرح الجريمة بعنايةٍ للبحث عن بقايا الدم، ويساعد على ذلك وضع المصابيح اليدوية بزاويةٍ من السطح المراد فحصه، بالإضافة إلى بخاخ لومينول (luminol) الذي يستطيع الكشف عن وجود وحتى تعقب كمياتٍ من الدماء، وتتواجد الاختبارات الافتراضية التي باستطاعتها تمييز الدم عن البقع الأخرى المائلة للحُمرَة في مسرح الجريمة، مثل بقع الكاتشب أو الصدأ.[106]

الفن
الدم هو أحد سوائل الجسم التي استخدمت في الفن،[107] على وجه الخصوص، أظهرت بعض العروض الدم كعنصر مرئي بارز، مثل عرض فينيس أكشنست هيرمان نيتش وإستفان كانتور وفرانكو بي، وليني لي، ورون آثي، ويانغ تشيتشاو، ولوكاس أبيلا، وكيرا أورايلي، إلى جانب تصوير أندريس سيرانو. صنع مارك كوين منحوتات باستخدام الدم المجمد، بما في ذلك قالب من رأسه مصنوع من دمه.
علم الأنساب والتاريخ العائلي
يستخدم مصطلح الدم في علم الأنساب للإشارة إلى أسلاف المرء وأصوله وخلفيته العرقية كما في كلمة سلالة. المصطلحات الأخرى التي يستخدم فيها الدم بمعنى تاريخ العائلة مثل الدم الأزرق الذي يدل على النبالة والدم الملكي الذي يدل على القرابة.
معرض صور
 عينات دم وريدي (الأغمق) وشرياني (الأفتح).
عينات دم وريدي (الأغمق) وشرياني (الأفتح). عينات دم مجلطة وأخرى غير مجلطة.
عينات دم مجلطة وأخرى غير مجلطة. رسم توضيحي لكيس نقل الدم.
رسم توضيحي لكيس نقل الدم. مكونات الدم والامراض.
مكونات الدم والامراض.
خلايا الدم الحمراء في الانسان مُكبرة 1000 مرة.
خلايا الدم الحمراء في الانسان مُكبرة 1000 مرة. خلايا الدم الحمراء في ضفدع مُكبرة 1000 مرة.
خلايا الدم الحمراء في ضفدع مُكبرة 1000 مرة. خلايا الدم الحمراء في سلحفاء مُكبرة 1000 مرة.
خلايا الدم الحمراء في سلحفاء مُكبرة 1000 مرة. خلايا الدم الحمراء في دجاجة مُكبرة 1000 مرة.
خلايا الدم الحمراء في دجاجة مُكبرة 1000 مرة. تحوي كريات الدم الحمراء الناضجة للطيور على نواة، ولكن في دم إناث بطريق جنتو البالغات، تم ملاحظة وجود كريات دم حمراء (B) غير منواة، ولكن بتواتر قليل للغاية.
تحوي كريات الدم الحمراء الناضجة للطيور على نواة، ولكن في دم إناث بطريق جنتو البالغات، تم ملاحظة وجود كريات دم حمراء (B) غير منواة، ولكن بتواتر قليل للغاية._(20670817635)-ar.jpg.webp) هناك تباين كبير في حجم كريات الدم الحمراء في الفقاريات، كما يوجد ارتباط بين حجم الخلية ووجود النواة. كريات الدم الحمراء عديمة النواة في الثدييات، أصغر بكثير من كريات معظم الفقاريات الأخرى.[108]
هناك تباين كبير في حجم كريات الدم الحمراء في الفقاريات، كما يوجد ارتباط بين حجم الخلية ووجود النواة. كريات الدم الحمراء عديمة النواة في الثدييات، أصغر بكثير من كريات معظم الفقاريات الأخرى.[108] كريات الدم الحمراء النموذجية للثدييات: (a) ينظر إليها من الأعلى، (b) ينظر إليها من الجانب مع تشكيل ظاهرة التنضد (c) كروية الشكل بسبب الماء، (d) كرية محززة (تقلصت وأصبحت شائكة) بسبب الملح. (c) و(d) لا تحدث عادة في الجسم الطبيعي. يرجع الشكلان الأخيران إلى الماء الذي يتم نقله من وإلى الخلايا بواسطة التناضح.
كريات الدم الحمراء النموذجية للثدييات: (a) ينظر إليها من الأعلى، (b) ينظر إليها من الجانب مع تشكيل ظاهرة التنضد (c) كروية الشكل بسبب الماء، (d) كرية محززة (تقلصت وأصبحت شائكة) بسبب الملح. (c) و(d) لا تحدث عادة في الجسم الطبيعي. يرجع الشكلان الأخيران إلى الماء الذي يتم نقله من وإلى الخلايا بواسطة التناضح. وعاء دموي تظهر فيه كرة دم حمراء (E) داخل التجويف الداخلي، خلايا البطانية مكونة للغلاف المبطن، وخلايا حوطية مكونة للغلاف الخارجي.
وعاء دموي تظهر فيه كرة دم حمراء (E) داخل التجويف الداخلي، خلايا البطانية مكونة للغلاف المبطن، وخلايا حوطية مكونة للغلاف الخارجي.
انظر أيضًا
- لزوجة الدم
- فصيلة الدم (غير بشري)
- فرط فوسفاتات الدم
- تحليل الدم
- ضغط الدم
- رهاب الدم
- محظورات الطعام والشراب
- لومينول، اختبار بصري للدم المتروكة في مسرح الجريمة.
مراجع
- مُعرِّف مَكنَز الفن والعمارة (AAT): https://www.getty.edu/vow/AATFullDisplay?find=&logic=AND¬e=&subjectid=300011797 — تاريخ الاطلاع: 6 سبتمبر 2019 — المخترع: معهد جيتي للبحوث
- "Definition of BLOOD". مؤرشف من الأصل في 23 مارس 2017. اطلع عليه بتاريخ 4 مارس 2017. الوسيط
|CitationClass=تم تجاهله (مساعدة) - Elert, Glenn (2012). "Volume of Blood in a Human". The Physics Factbook. his students. مؤرشف من الأصل في 01 نوفمبر 2012. اطلع عليه بتاريخ 01 نوفمبر 2012 الوسيط
|CitationClass=تم تجاهله (مساعدة) - Edwards Lifesciences LLC - Normal Hemodynamic Parameters – Adultنسخة محفوظة 10 November 2010 على موقع واي باك مشين. 2009
- Shuster, Carl N (2004). "Chapter 11: A blue blood: the circulatory system". In Shuster, Carl N Jr; Barlow, Robert B; Brockmann, H. Jane (المحررون). The American Horseshoe Crab. دار نشر جامعة هارفارد. صفحات 276–77. ISBN 0-674-01159-7. مؤرشف من الأصل في 24 يناير 2020. الوسيط
|CitationClass=تم تجاهله (مساعدة) - The Franklin Institute Inc. "Blood – The Human Heart". مؤرشف من الأصل في 5 مارس 2009. اطلع عليه بتاريخ 19 مارس 2009. الوسيط
|CitationClass=تم تجاهله (مساعدة) - "ما هي وظائف الدم الرئيسيه .. مكونات الدم ووظائفها وخصائصه". موقع محتويات. 2020-11-14. مؤرشف من الأصل في 13 يناير 2021. اطلع عليه بتاريخ 13 يناير 2021. الوسيط
|CitationClass=تم تجاهله (مساعدة) - Alberts, Bruce (2012). "Table 22-1 Blood Cells". Molecular Biology of the Cell. NCBI Bookshelf. مؤرشف من الأصل في 27 مارس 2018. اطلع عليه بتاريخ 1 نوفمبر 2012. الوسيط
|CitationClass=تم تجاهله (مساعدة) - Elert, Glenn (2012). "Volume of Blood in a Human". The Physics Factbook. مؤرشف من الأصل في 03 نوفمبر 2012. اطلع عليه بتاريخ 01 نوفمبر 2012. الوسيط
|CitationClass=تم تجاهله (مساعدة) - Shmukler, Michael (2004). "Density of Blood". The Physics Factbook. مؤرشف من الأصل في 19 سبتمبر 2006. اطلع عليه بتاريخ 4 أكتوبر 2006. الوسيط
|CitationClass=تم تجاهله (مساعدة) - "Composition of the Blood | SEER Training". training.seer.cancer.gov. مؤرشف من الأصل في 16 أكتوبر 2020. الوسيط
|CitationClass=تم تجاهله (مساعدة) - "معلومات عن تدفق الدم على موقع britannica.com". britannica.com. مؤرشف من الأصل في 9 يوليو 2015. الوسيط
|CitationClass=تم تجاهله (مساعدة) - "Medical Encyclopedia: RBC count". Medline Plus. مؤرشف من الأصل في 21 أكتوبر 2007. اطلع عليه بتاريخ 18 نوفمبر 2007. الوسيط
|CitationClass=تم تجاهله (مساعدة) - Tallitsch, Robert B.; Frederic, Martini; Michael J., Timmons (2006). Human anatomy (الطبعة 5th). San Francisco: Pearson/Benjamin Cummings. صفحة 529. ISBN 978-0-8053-7211-3. الوسيط
|CitationClass=تم تجاهله (مساعدة) - Ganong, William F. (2003). Review of medical physiology (الطبعة 21). New York: Lange Medical Books/McGraw-Hill. صفحة 518. ISBN 978-0-07-121765-1. مؤرشف من الأصل في 1 أغسطس 2020. الوسيط
|CitationClass=تم تجاهله (مساعدة) - F. C. Garg (2005). Experimental Microbiology (باللغة الإنجليزية) (الطبعة first edition). CBS Publishers & Distributors. صفحة 48. مؤرشف من الأصل في 11 أبريل 2020. الوسيط
|CitationClass=تم تجاهله (مساعدة)صيانة CS1: نص إضافي (link) - C. Guyton, M.D; John E. Hall, Ph.D (1996). "32". In translated to arabic by The world Health Organization (المحرر). Textbook of Medical physiology [المرجع في الفيزيولوجيا الطبية] (الطبعة التاسعة). الوسيط
|CitationClass=تم تجاهله (مساعدة) - "Blood Cells". مؤرشف من الأصل في 23 يوليو 2016. اطلع عليه بتاريخ أغسطس 2020. الوسيط
|CitationClass=تم تجاهله (مساعدة); تحقق من التاريخ في:|تاريخ الوصول=(مساعدة) - "معلومات عن خلية الدم البيضاء على موقع thes.bncf.firenze.sbn.it". thes.bncf.firenze.sbn.it. مؤرشف من الأصل في 18 ديسمبر 2019. الوسيط
|CitationClass=تم تجاهله (مساعدة) - "معلومات عن خلية الدم البيضاء على موقع jstor.org". jstor.org. مؤرشف من الأصل في 13 مارس 2020. الوسيط
|CitationClass=تم تجاهله (مساعدة) - "معلومات عن خلية الدم البيضاء على موقع psh.techlib.cz". psh.techlib.cz. مؤرشف من الأصل في 18 ديسمبر 2019. الوسيط
|CitationClass=تم تجاهله (مساعدة) - Exploring Medical Language: A Student-Directed Approach (الطبعة 7th). St. Louis, Missouri, US: Mosby Elsevier. 2008. صفحة 398. ISBN 978-0-323-04950-4. الوسيط
|CitationClass=تم تجاهله (مساعدة) - "Ways to Keep Your Blood Plasma Healthy". مؤرشف من الأصل في November 1, 2013. اطلع عليه بتاريخ 10 نوفمبر 2011. الوسيط
|CitationClass=تم تجاهله (مساعدة) - Dennis O'Neil (1999). "Blood Components". Palomar College. مؤرشف من الأصل في June 5, 2013. الوسيط
|CitationClass=تم تجاهله (مساعدة) - Tuskegee University (May 29, 2013). "Chapter 9 Blood". tuskegee.edu. مؤرشف من الأصل في 28 ديسمبر 2013. الوسيط
|CitationClass=تم تجاهله (مساعدة) - Laki K (Dec 8, 1972). "Our ancient heritage in blood clotting and some of its consequences". Annals of the New York Academy of Sciences. 202: 297–307. Bibcode:1972NYASA.202..297L. doi:10.1111/j.1749-6632.1972.tb16342.x. PMID 4508929. الوسيط
|CitationClass=تم تجاهله (مساعدة) - Jain NC (1975). "A scanning electron microscopic study of platelets of certain animal species". Thrombosis et diathesis haemorrhagica. 33 (3): 501–07. PMID 1154309. الوسيط
|CitationClass=تم تجاهله (مساعدة) - Movat HZ; Weiser WJ; Glynn MF; Mustard JF (1965). "Platelet phagocytosis and aggregation". J. Cell Biol. 27 (3): 531–43. doi:10.1083/jcb.27.3.531. PMC 2106759. PMID 4957257. الوسيط
|CitationClass=تم تجاهله (مساعدة) - CBBS: Washed and volume-reduced Plateletpheresis units. Cbbsweb.org (2001-10-25). Retrieved on 2011-11-14. نسخة محفوظة 14 أبريل 2014 على موقع واي باك مشين.
- Waugh, Anne; Grant, Allison (2007). "2". Anatomy and Physiology in Health and Illness (الطبعة Tenth). Churchill Livingstone Elsevier. صفحة 22. ISBN 978-0-443-10102-1. الوسيط
|CitationClass=تم تجاهله (مساعدة) - Acid-Base Regulation and Disorders في الطبعة المهنية لدليل ميرك للتشخيص والعلاج
- Lehninger. Principles of Biochemistry (الطبعة 6th). صفحة 169. الوسيط
|CitationClass=تم تجاهله (مساعدة) - Romer, Alfred Sherwood; Parsons, Thomas S. (1977). The Vertebrate Body. Philadelphia: Holt-Saunders International. صفحات 404–406. ISBN 978-0-03-910284-5. الوسيط
|CitationClass=تم تجاهله (مساعدة) - Hajar, Rachel (1999). "The Greco-Islamic Pulse". Heart Views. 1 (4): 136–140 [138]. مؤرشف من الأصل في 09 يناير 2014. الوسيط
|CitationClass=تم تجاهله (مساعدة) - Reflections, Chairman's (2004). "Traditional Medicine Among Gulf Arabs, Part II: Blood-letting". Heart Views. 5 (2): 74–85 [80]. مؤرشف من الأصل في 11 سبتمبر 2007. الوسيط
|CitationClass=تم تجاهله (مساعدة) نسخة محفوظة 7 فبراير 2012 على موقع واي باك مشين. - "History of Medicine: Sushruta – the Clinician – Teacher par Excellence"نسخة محفوظة October 10, 2008, على موقع واي باك مشين., Indian J Chest Dis Allied Sci Vol.49 pp.243-4, National Informatics Centre (Government of India).
- Harvey, William (1628). "Exercitatio Anatomica de Motu Cordis et Sanguinis in Animalibus" (باللغة اللاتينية). مؤرشف من الأصل في 27 نوفمبر 2010. الوسيط
|CitationClass=تم تجاهله (مساعدة) - "Hematopoiesis from Pluripotent Stem Cells". Antibodies Resource Library. ThermoFisher Scientific. مؤرشف من الأصل في 16 ديسمبر 2016. اطلع عليه بتاريخ 25 أبريل 2020. الوسيط
|CitationClass=تم تجاهله (مساعدة) - Birbrair, Alexander; Frenette, Paul S. (2016-03-01). "Niche heterogeneity in the bone marrow". Annals of the New York Academy of Sciences (باللغة الإنجليزية). 1370 (1): 82–96. Bibcode:2016NYASA1370...82B. doi:10.1111/nyas.13016. ISSN 1749-6632. PMC 4938003. PMID 27015419. الوسيط
|CitationClass=تم تجاهله (مساعدة) - Semester 4 medical lectures at Uppsala University 2008 by Leif Jansson
- Williams, Peter W.; Gray, Henry David (1989). Gray's anatomy (الطبعة 37th). New York: C. Livingstone. ISBN 978-0-443-02588-4. الوسيط
|CitationClass=تم تجاهله (مساعدة) - Nguyen-Lefebvre, Anh Thu; Horuzsko, Anatolij (2015). "Kupffer Cell Metabolism and Function". Journal of Enzymology and Metabolism. 1 (1). PMC 4771376. PMID 26937490. الوسيط
|CitationClass=تم تجاهله (مساعدة) - Dixon, Laura J.; Barnes, Mark; Tang, Hui; Pritchard, Michele T.; Nagy, Laura E. (April 2013). "Kupffer Cells in the Liver". Comprehensive Physiology. 3 (2): 785–797. doi:10.1002/cphy.c120026. ISSN 2040-4603. PMC 4748178. PMID 23720329. الوسيط
|CitationClass=تم تجاهله (مساعدة) - Frederic, Martini (2009). Fundamentals of anatomy & physiology. Nath, Judi Lindsley (الطبعة 8th). San Francisco: Pearson/Benjamin Cummings. صفحة 657. ISBN 978-0321539106. OCLC 173683666. الوسيط
|CitationClass=تم تجاهله (مساعدة) - "Equality of the in vivo and in vitro oxygen-binding capacity of haemoglobin in patients with severe respiratory disease". British Journal of Anaesthesia. 53 (12): 1325–8. December 1981. doi:10.1093/bja/53.12.1325. PMID 7317251. S2CID 10029560. الوسيط
|CitationClass=تم تجاهله (مساعدة) - Costanzo, Linda S. (2007). Physiology. Hagerstown, Maryland: Lippincott Williams & Wilkins. ISBN 978-0-7817-7311-9. مؤرشف من الأصل في 1 أغسطس 2020. الوسيط
|CitationClass=تم تجاهله (مساعدة) - Edwards Lifesciences LLC – Normal Hemodynamic Parameters – Adult نسخة محفوظة 10 November 2010 على موقع واي باك مشين. 2009
- "Ventilatory Physiology and Endurance". 23 March 2010. مؤرشف من الأصل في 23 مارس 2010. اطلع عليه بتاريخ 04 مارس 2017. الوسيط
|CitationClass=تم تجاهله (مساعدة) - Transplant Support- Lung, Heart/Lung, Heart MSN groups نسخة محفوظة 21 أغسطس 2016 على موقع واي باك مشين.
- "Limitations to systemic and locomotor limb muscle oxygen delivery and uptake during maximal exercise in humans". The Journal of Physiology. 566 (Pt 1): 273–85. July 2005. doi:10.1113/jphysiol.2005.086025. PMC 1464731. PMID 15860533. الوسيط
|CitationClass=تم تجاهله (مساعدة) - "Blood gas and Saturation measurements". 25 September 2010. مؤرشف من الأصل في 25 سبتمبر 2010. اطلع عليه بتاريخ 04 مارس 2017. الوسيط
|CitationClass=تم تجاهله (مساعدة) - "Lecture Notes-20". 2 May 1999. مؤرشف من الأصل في 02 مايو 1999. اطلع عليه بتاريخ 04 مارس 2017. الوسيط
|CitationClass=تم تجاهله (مساعدة) - Guyton, Arthur C.; John E. Hall (2006). Textbook of Medical Physiology (الطبعة 11). Philadelphia: Elsevier Saunders. صفحة 511. ISBN 978-0721602400. الوسيط
|CitationClass=تم تجاهله (مساعدة) - Martini, Frederic; et al. (2007). Anatomy and Physiology. Rex Bookstore, Inc. صفحة 643. ISBN 9789712348075. مؤرشف من الأصل في 1 مايو 2016. الوسيط
|CitationClass=تم تجاهله (مساعدة) - Vander's Human Physiology reported similar numbers: 60% carried as bicarbonate, 30% bound to hemoglobin as carbaminohemoglobin, and 10% physically dissolved. Widmaier, Eric P.; Raff, Hershel; Strang, Kevin T. (2003). Vander's Human Physiology (الطبعة 9th). ماكجرو هيل التعليم. p. 493 (ch. Respiratory physiology § Transport of carbon dioxide in blood). ISBN 978-0-07-288074-8. الوسيط
|CitationClass=تم تجاهله (مساعدة) - Maton, Anthea; Jean Hopkins; Charles William McLaughlin; Susan Johnson; Maryanna Quon Warner; David LaHart; Jill D. Wright (1993). Human Biology and Health. Englewood Cliffs, New Jersey, US: Prentice Hall. ISBN 978-0139811760. مؤرشف من الأصل في 30 نوفمبر 2020. الوسيط
|CitationClass=تم تجاهله (مساعدة) - Nelson, D. L.; Cox, M. M. (2000). Lehninger Principles of Biochemistry, 3rd ed. New York, : Worth Publishers. p. 217, (ردمك 1572599316).
- Jensen, Frank B (2009). "The dual roles of red blood cells in tissue oxygen delivery: oxygen carriers and regulators of local blood flow". Journal of Experimental Biology. 212 (Pt 21): 3387–93. doi:10.1242/jeb.023697. PMID 19837879. الوسيط
|CitationClass=تم تجاهله (مساعدة) - Vittet D (November 2014). "Lymphatic collecting vessel maturation and valve morphogenesis". Microvascular Research. 96: 31–7. doi:10.1016/j.mvr.2014.07.001. PMID 25020266. الوسيط
|CitationClass=تم تجاهله (مساعدة) - Heppell C, Richardson G, Roose T (January 2013). "A model for fluid drainage by the lymphatic system". Bulletin of Mathematical Biology. 75 (1): 49–81. doi:10.1007/s11538-012-9793-2. PMID 23161129. S2CID 20438669. الوسيط
|CitationClass=تم تجاهله (مساعدة) - Kanosue, K.; Crawshaw, L. I.; Nagashima, K.; Yoda, T. (2009). "Concepts to utilize in describing thermoregulation and neurophysiological evidence for how the system works". European Journal of Applied Physiology. 109 (1): 5–11. doi:10.1007/s00421-009-1256-6. PMID 19882166. S2CID 11103870. مؤرشف من الأصل في 3 فبراير 2020. الوسيط
|CitationClass=تم تجاهله (مساعدة) - Eva V. Osilla; Jennifer L. Marsidi; Sandeep Sharma (2020). "Physiology, Temperature Regulation". Statpearls. PMID 29939615. الوسيط
|CitationClass=تم تجاهله (مساعدة) - Jones, S., Martin, R., & Pilbeam, D. (1994) The Cambridge Encyclopedia of Human Evolution". Cambridge: Cambridge University Press
- Harrison, G.A., Tanner, J.M., Pilbeam, D.R., & Baker, P.T. (1988) Human Biology: An introduction to human evolution, variation, growth, and adaptability. (3rd ed). Oxford: Oxford University Press
- Guyton and Hall Textbook of Medical Physiology. Saunders. 2015. صفحة 204. ISBN 978-1455770052. الوسيط
|CitationClass=تم تجاهله (مساعدة) - Spiders: circulatory system. مؤرشف من الأصل في 12 نوفمبر 2007. اطلع عليه بتاريخ 25 نوفمبر 2007. الوسيط
|CitationClass=تم تجاهله (مساعدة) - Hagner-Holler, Silke; Schoen, Axel; Erker, Wolfgang; Marden, James H.; Rupprecht, Rainer; Decker, Heinz; Burmester, Thorsten (2004-01-20). "A respiratory hemocyanin from an insect". Proceedings of the National Academy of Sciences (باللغة الإنجليزية). 101 (3): 871–874. Bibcode:2004PNAS..101..871H. doi:10.1073/pnas.0305872101. ISSN 0027-8424. PMC 321773. PMID 14715904. الوسيط
|CitationClass=تم تجاهله (مساعدة) - Hankeln, Thomas; Jaenicke, Viviane; Kiger, Laurent; Dewilde, Sylvia; Ungerechts, Guy; Schmidt, Marc; Urban, Joachim; Marden, Michael C.; Moens, Luc; Burmester, Thorsten (2002-06-04). "Characterization ofDrosophilaHemoglobin". Journal of Biological Chemistry. 277 (32): 29012–29017. doi:10.1074/jbc.m204009200. ISSN 0021-9258. PMID 12048208. الوسيط
|CitationClass=تم تجاهله (مساعدة) - "معلومات عن فئات الدم على موقع d-nb.info". d-nb.info. مؤرشف من الأصل في 09 ديسمبر 2019. الوسيط
|CitationClass=تم تجاهله (مساعدة) - "معلومات عن فئات الدم على موقع thes.bncf.firenze.sbn.it". thes.bncf.firenze.sbn.it. مؤرشف من الأصل في 31 أغسطس 2019. الوسيط
|CitationClass=تم تجاهله (مساعدة) - "معلومات عن فئات الدم على موقع id.ndl.go.jp". id.ndl.go.jp. مؤرشف من الأصل في 06 أبريل 2020. الوسيط
|CitationClass=تم تجاهله (مساعدة) - "RBC compatibility table". American National Red Cross. December 2006. مؤرشف من الأصل في 13 سبتمبر 2008. اطلع عليه بتاريخ 15 يوليو 2008. الوسيط
|CitationClass=تم تجاهله (مساعدة) - Blood types and compatibility نسخة محفوظة 2010-04-19 على موقع واي باك مشين. bloodbook.com
- Prahl. "Optical Absorption of Hemoglobin". مؤرشف من الأصل في 5 يناير 2002. اطلع عليه بتاريخ 30 ديسمبر 2012. الوسيط
|CitationClass=تم تجاهله (مساعدة) - "Why do veins appear blue? A new look at an old question" (PDF). Applied Optics. 35 (7): 1151. March 1996. Bibcode:1996ApOpt..35.1151K. doi:10.1364/AO.35.001151. PMID 21085227. مؤرشف من الأصل (PDF) في 10 فبراير 2012. الوسيط
|CitationClass=تم تجاهله (مساعدة) - "Parasites in a biodiversity hotspot: a survey of hematozoa and a molecular phylogenetic analysis of Plasmodium in New Guinea skinks". The Journal of Parasitology. 92 (4): 770–7. August 2006. doi:10.1645/GE-693R.1. PMID 16995395. S2CID 1937837. الوسيط
|CitationClass=تم تجاهله (مساعدة) - Shuster, Carl N (2004). "Chapter 11: A blue blood: the circulatory system". In Shuster, Carl N Jr; Barlow, Robert B; Brockmann, H. Jane (المحررون). The American Horseshoe Crab. Harvard University Press. صفحات 276–277. ISBN 978-0-674-01159-5. الوسيط
|CitationClass=تم تجاهله (مساعدة) - Carnegie Library of Pittsburgh, The Handy Science Answer Book, p. 465, Visible Ink Press, 2011 (ردمك 1578593212).
- Underwood, Eric J. (1962). Trace elements in human and animal nutrition. Academic Press. صفحة 353. OCLC 598742364. الوسيط
|CitationClass=تم تجاهله (مساعدة) - Boeri, Enzo (June 1952). "The determination of hemovanadin and its oxidation potential". Archives of Biochemistry and Biophysics. 37 (2): 449–456. doi:10.1016/0003-9861(52)90205-1. الوسيط
|CitationClass=تم تجاهله (مساعدة) - "Reference Ranges and What They Mean". Lab Tests Online (USA). مؤرشف من الأصل في 26 يونيو 2020. اطلع عليه بتاريخ 22 يونيو 2013. الوسيط
|CitationClass=تم تجاهله (مساعدة) - Normal Reference Range Table نسخة محفوظة 2011-12-25 على موقع واي باك مشين. from The University of Texas Southwestern Medical Center at Dallas. Used in Interactive Case Study Companion to Pathologic basis of disease.
- Derived from mass values using 64,500 g/mol. This molar mass was taken from: "Performance of near-infrared spectroscopy in measuring local O2 consumption and blood flow in skeletal muscle". J Appl Physiol. 90 (2): 511–19. 2001. doi:10.1152/jappl.2001.90.2.511. PMID 11160049. S2CID 15468862. الوسيط
|CitationClass=تم تجاهله (مساعدة) - Last page of Deepak A. Rao; Le, Tao; Bhushan, Vikas (2007). First Aid for the USMLE Step 1 2008 (First Aid for the Usmle Step 1). McGraw-Hill Medical. ISBN 978-0-07-149868-5. مؤرشف من الأصل في 1 أغسطس 2020. الوسيط
|CitationClass=تم تجاهله (مساعدة) - Blood Test Results – Normal Ranges نسخة محفوظة 2012-11-02 على موقع واي باك مشين. Bloodbook.Com
- Reference range list from Uppsala University Hospital ("Laborationslista"). Artnr 40284 Sj74a. Issued on April 22, 2008
- "What Is Anemia? – NHLBI, NIH". www.nhlbi.nih.gov. مؤرشف من الأصل في 20 يناير 2016. اطلع عليه بتاريخ 31 يناير 2016. الوسيط
|CitationClass=تم تجاهله (مساعدة) - Stedman's medical Dictionary (الطبعة 28th). Philadelphia: Lippincott Williams & Wilkins. 2006. صفحة Anemia. ISBN 978-0-7817-3390-8. مؤرشف من الأصل في 25 أكتوبر 2020. الوسيط
|CitationClass=تم تجاهله (مساعدة) - "What You Need To Know About™ Leukemia". National Cancer Institute. 2013-12-23. مؤرشف من الأصل في 6 أكتوبر 2014. اطلع عليه بتاريخ 18 يونيو 2014. الوسيط
|CitationClass=تم تجاهله (مساعدة) - [Polycythemia vera EBSCO database] verified by URAC; accessed from مستشفى ماونت سيناي
- "Polycythemia vera-associated pruritus and its management". Eur J Clin Invest. 40 (9): 828–34. 2010. doi:10.1111/j.1365-2362.2010.02334.x. PMID 20597963. الوسيط
|CitationClass=تم تجاهله (مساعدة) - منظمة الصحة العالمية، ميزة نمو خلايا CD34+ في التثليث الصبغي 8 لمتلازمة خلل التنسج النخاعي العالية الخطورة بالرغم من تحسن إشارات الاستماتة نسخة محفوظة 05 نوفمبر 2018 على موقع واي باك مشين.
- Franchini, M; Mannucci, PM (December 2013). "Acquired haemophilia A: a 2013 update". Thrombosis and Haemostasis. 110 (6): 1114–20. CiteSeerX = 10.1.1.684.7962 10.1.1.684.7962. doi:10.1160/TH13-05-0363. PMID 24008306. الوسيط
|CitationClass=تم تجاهله (مساعدة) - "Hemophilia B: MedlinePlus Medical Encyclopedia". www.nlm.nih.gov. مؤرشف من الأصل في 05 يوليو 2016. اطلع عليه بتاريخ 21 يونيو 2016. الوسيط
|CitationClass=تم تجاهله (مساعدة) - "معلومات عن اعتلال خثري على موقع ncim-stage.nci.nih.gov". ncim-stage.nci.nih.gov. مؤرشف من Metathesaurus&code=C0005779 الأصل تحقق من قيمة
|مسار=(مساعدة) في 10 سبتمبر 2019. الوسيط|CitationClass=تم تجاهله (مساعدة) - "معلومات عن أهبة التخثر على موقع human-phenotype-ontology.org". human-phenotype-ontology.org. مؤرشف من الأصل في 09 ديسمبر 2019. الوسيط
|CitationClass=تم تجاهله (مساعدة) - Health, National Center for Environmental (30 December 2015). "Carbon Monoxide Poisoning – Frequently Asked Questions". www.cdc.gov (باللغة الإنجليزية). مؤرشف من الأصل في 05 يوليو 2017. اطلع عليه بتاريخ 02 يوليو 2017. الوسيط
|CitationClass=تم تجاهله (مساعدة) - Guzman, JA (October 2012). "Carbon monoxide poisoning". Critical Care Clinics. 28 (4): 537–48. doi:10.1016/j.ccc.2012.07.007. PMID 22998990. الوسيط
|CitationClass=تم تجاهله (مساعدة) - Schottke, David (2016). Emergency Medical Responder: Your First Response in Emergency Care (باللغة الإنجليزية). Jones & Bartlett Learning. صفحة 224. ISBN 978-1284107272. مؤرشف من الأصل في 10 سبتمبر 2017. اطلع عليه بتاريخ 02 يوليو 2017. الوسيط
|CitationClass=تم تجاهله (مساعدة) - Screening donated blood for transfusion-transmissible infections: recommendations. World Health Organization. 2009. ISBN 978-92-4-154788-8. مؤرشف من الأصل (PDF) في 16 أغسطس 2020. الوسيط
|CitationClass=تم تجاهله (مساعدة) - Webster, Joan; Bell-Syer, Sally EM; Foxlee, Ruth (2015-02-12). Cochrane Wounds Group (المحرر). "Skin preparation with alcohol versus alcohol followed by any antiseptic for preventing bacteraemia or contamination of blood for transfusion". Cochrane Database of Systematic Reviews (باللغة الإنجليزية). 2015 (2): CD007948. doi:10.1002/14651858.CD007948.pub3. PMC 7185566. PMID 25674776. الوسيط
|CitationClass=تم تجاهله (مساعدة) - Flynn, Edward (2007). "Pharmacokinetic Parameters". xPharm: The Comprehensive Pharmacology Reference. Elsevier. صفحات 1–3. doi:10.1016/b978-008055232-3.60034-0. ISBN 978-0-08-055232-3. الوسيط
|CitationClass=تم تجاهله (مساعدة) - "Bloodletting". British Science Museum. 2009. مؤرشف من الأصل في 05 ديسمبر 2015. اطلع عليه بتاريخ 12 يوليو 2009. الوسيط
|CitationClass=تم تجاهله (مساعدة) - Mestel, Rosie (6 August 2001). "Modern Bloodletting and Leeches". Los Angeles Times. مؤرشف من الأصل في 16 ديسمبر 2018. اطلع عليه بتاريخ 12 يوليو 2009. الوسيط
|CitationClass=تم تجاهله (مساعدة) - B.) Anderson, Julie, Emm Barnes, and Enna Shackleton. "The Art of Medicine: Over 2,000 Years of Images and Imagination [Hardcover]." The Art of Medicine: Over 2, 000 Years of Images and Imagination: Julie Anderson, Emm Barnes, Emma Shackleton: (ردمك 978-0226749365): The Ilex Press Limited, 2013.
- Robinson, James L. (2008). "Blood residue and bloodstains". In Ayn Embar-seddon, Allan D. Pass (eds.) (المحرر). Forensic Science. Salem Press. صفحة 152. ISBN 978-1-58765-423-7. الوسيط
|CitationClass=تم تجاهله (مساعدة)صيانة CS1: نص إضافي: قائمة المحررون (link) - "Nostalgia" Artwork in blood نسخة محفوظة 8 January 2009 على موقع واي باك مشين.
- Gulliver, G. (1875). "On the size and shape of red corpuscles of the blood of vertebrates, with drawings of them to a uniform scale, and extended and revised tables of measurements". Proceedings of the Zoological Society of London. 1875: 474–495. الوسيط
|CitationClass=تم تجاهله (مساعدة)
- بوابة علم الأحياء
- بوابة طب
